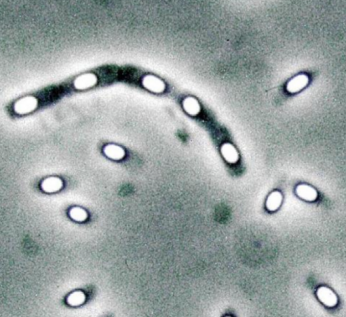
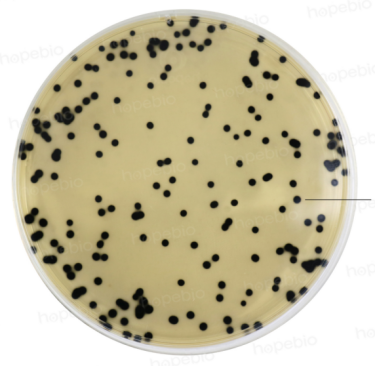

天凉不放冰箱,是在给这种菌”建别墅“吗?
最近降温啦,凉爽的秋天终于来咯!

不少人(特别是家里的老辈子)可能会想:“天气凉了,剩饭剩菜不用放冰箱了吧?反正不容易坏,下一顿热起来还更方便。”
等等——打住!这时候一个“隐藏杀手”可能已经悄盯上你的餐桌了,它就是——产气荚膜梭菌!

我们先来讲讲梭菌大家族——梭菌属是一群革兰阳性菌,他们的共同特点是都能产生芽孢,芽孢是细菌的休眠体,当环境恶劣时细菌会停止繁殖变身芽孢状态,其含水量极低,能经受高温、紫外线,电离辐射以及多种化学物质灭杀,等条件合适时芽孢又会重新形成细菌而继续繁殖。因此芽孢堪称整个生物界中抗逆性最强的生命体,

图注:产气荚膜梭菌能变成“芽孢”休眠,像穿了防护服一样,耐热又耐寒,生命力超顽强!
而梭菌因芽孢直径大于菌体宽度,使菌体膨大呈梭形而得名。其广泛分布于自然界中,存在于土壤、人和动物肠道中。多数为非致病菌,少数为致病菌。常见致病厌氧芽孢梭菌主要有破伤风梭菌、产气荚膜梭菌、肉毒梭菌和艰难梭菌等。

图注:产气荚膜梭菌在TSC平板上的菌落形态(左图),我愿称之为“邪恶黑波点”,很明显的特征就是又大又黑又圆,并且散发着恶臭。
我们今天讲的产气荚膜梭菌和它的有名亲戚破伤风梭菌、肉毒梭菌一样,也是梭菌大军中能引起人类致病的一员大将——它喜欢在没有氧气的环境里生活。土壤、污水、食物里都可能藏着它。

因为和它的亲戚们相比,它还挺有个性——
个性一:它特别能“产气”,是临床上引起气性坏疽最多见的一种梭菌。能分解肌肉和结缔组织中的糖,产生大量气体,影响血液供应,造成组织大面积坏死。



图注:气性坏疽示意图(右图)产气荚膜梭菌会分解乳糖使含铁牛乳培养基产生汹涌发酵的现象(左图)
个性二:它穿了一层叫“荚膜”的“衣服”,这层“衣服”对它的生存来说至关重要——可以保护它抵御不良环境;帮它抵抗白细胞的吞噬作用;还可以帮它选择性黏附在细胞表面,甚至还能帮它攻击靶细胞,能守能攻——一个字:牛!
个性三:它能够产生肠毒素继而引起食物中毒。
如果不小心吃下被它污染的食物,可能会引起食物中毒,症状通常是:
· 腹泻(一天十几次都有可能)
· 肚子绞痛、胀气
· 拉出来的多是水样便,还带着一股腐败的恶臭
· 呕吐、发烧的情况比较少见。

大多数健康成年人1–2天就能自己好转,但老人、小孩或免疫力较低的人要特别当心,严重时可能引发坏死性肠炎或感染性休克!
· 肉类和肉制品:鸡肉、猪肉、牛肉、火腿、香肠等
· 豆类:红豆、黄豆等
· 海鲜
· 剩饭剩菜:炖菜、汤、米饭、面条等






这些烹饪习惯很危险!
· 大块肉没煮透(比如整鸡、大块炖肉中心温度不够)
· 煮好的食物放凉得太慢,长时间处于“温吞吞”的状态
· 剩菜加热不彻底
· 食堂大锅菜储存不当
·煮熟煮透:肉类尽量切小块再煮,确保中心温度达到70℃以上,看不到血丝血水。
·快速冷却:剩菜别在常温下放太久,分装成小份,及时放进冰箱(4℃以下)。
·充分加热:吃之前一定要彻底加热,汤汁煮沸才行!
·注意卫生:厨房工具生熟分开,处理生肉后认真洗手,冰箱定期清洁。

天凉了,美食依旧温暖人心,
但也别忘了:剩菜要存好,加热要彻底!
祝大家吃得开心,也吃得安心~

参考文献:
[1] Kiu R, Hall LJ. An update on the human and animal enteric pathogen Clostridium perfringens. [J] Emerg Microbes Infect. 2018,7(1):141.
[2] Brynestad S, Granum PE. Clostridium perfringens and foodborne infections. [J] Int J Food Microbiol. 2002,74(3):195-202.
[3] Komatsu H, Inui A, Sogo T, Fujisawa T. Clostridium perfringens. [J] Nihon Rinsho. 2012,70(8):1357-61.
图片来源于网络。
编辑:健教科


 游客
游客















